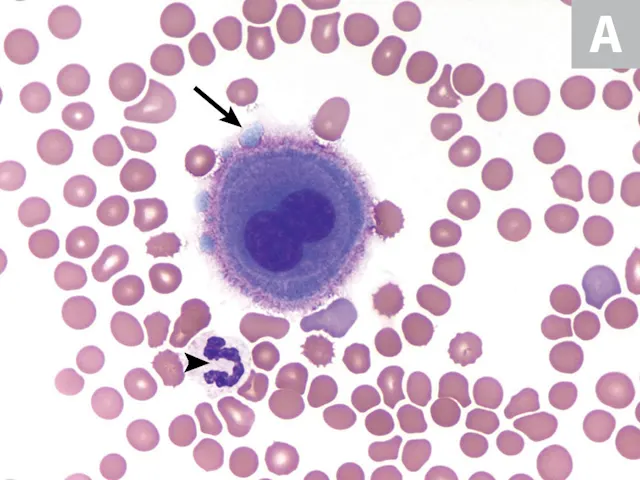
thumbnail image

Effusion Cytology
Maxey Wellman, DVM, MS, PhD, DACVP (Clinical Pathology), The Ohio State University
M. Judith Radin, DVM, PhD, DACVP (Clinical Pathology), The Ohio State University

Effusions result from increased hydrostatic pressure or vascular permeability, altered oncotic pressure, or impaired lymphatic drainage. Effusions into body cavities (eg, thorax, abdomen, pericardial sac) are most commonly associated with inflammation, neoplasia, hemorrhage, trauma, obstruction, or leakage from the urinary or biliary tracts. Effusion cytology is relatively noninvasive and inexpensive and often provides an accurate diagnosis or contributes to diagnostic planning and prognosis.
Clinical history and physical examination findings are helpful in establishing differential diagnoses. For example, a young cat with weight loss and hyperproteinemia is more likely to have an inflammatory effusion from FIP than from a neoplastic process. Likewise, an older large-breed dog with acute collapse and a large splenic mass is more likely to have hemorrhagic effusion from a ruptured hemangiosarcoma than from a transudate associated with hyperadrenocorticism.
Typically, only several milliliters of fluid are present in the thorax, abdomen, and pericardial sac in dogs and cats. The fluid is clear, colorless, and minimally cellular (<3 × 109 cells/L) with a relatively low total protein concentration (<2.5 g/dL).1 There is some variability in classifying effusions, and several schemes and algorithms are presented in the literature.1,2 Recent classification schemes have simplified effusion categories into low-protein transudates (<2.5 g protein/dL and <3 × 109 nucleated cells/L), high-protein transudates (≥2.5 g protein/dL and <3 × 109 nucleated cells/L), and exudates (≥2.5 g protein/dL and ≥3 × 109 nucleated cells/L).1 A hemorrhagic effusion is suggested if the fluid packed cell volume is ≥25% that of the peripheral blood or if >0.5 × 1012 RBCs/L are present.1,3 Neoplastic processes can be associated with any fluid type, emphasizing the importance of microscopic evaluation.
Examples of the types of cells that occur in effusions are included in this image gallery.
FIGURE 1A
Mesothelial cells. Thoracic fluid from a dog (A). Body cavities are lined by mesothelial cells, which are present in variable numbers in most effusions. Mesothelial cells (arrow) are much larger than neutrophils (arrowhead) and are characterized by abundant basophilic cytoplasm that often has an eosinophilic fringe border or corona. The cytoplasmic blebs seen along the upper left border of the cell (tip of arrow) likely are an artifact. Round, central nuclei have stippled chromatin and may have visible nucleoli. Binucleated cells are not uncommon. Wright-Giemsa stain; magnification 1000×